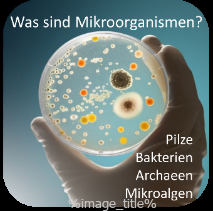
Downloads-005 Downloads-005

Wissenschaftsvermittlung mit Musik
Der Mikrobiologe Dr. Heribert Insam, vormalig Universitätsprofessor und Leiter des Instituts für Mikrobiologie der Universität Innsbruck, sowie die BerufsmusikerInnen Patrizia Grawe (voice) und Sebastian Schweiger (piano) erzählen Fakten und wecken Emotionen.
Die Wissenschaftsskepsis soll überwunden werden. Die wichtige Rolle von Mikroorganismen bei der Entstehung von Treibhausgasen wird vermittelt und soll dazu beitragen, den Klimawandel besser zu verstehen und Handlungsmöglichkeiten für den Einzelnen abzuleiten.
Die Entwicklung des Formats wurde gefördert vom Interreg-Projekt CEDRIC, dessen wissenschaftlicher Inhalt die Transplantation pflanzlicher Mikrobiome von Standorten südlich der Alpen auf solche nördlich der Alpen ist. Das Ziel ist verbesserter Wuchs nach Klimaveränderungen.
Buchungsanfragen für Soundsof Science per email-Anfrage hinsam@mikromondo.org
Näheres unter der Webseite soundsofscience
FREIRAD – Kulturton mit Anna Greissing: Mitschnitt des Vortrages Mikroben und Klima beim MINT-Festival Lienz vom 29.1.2025